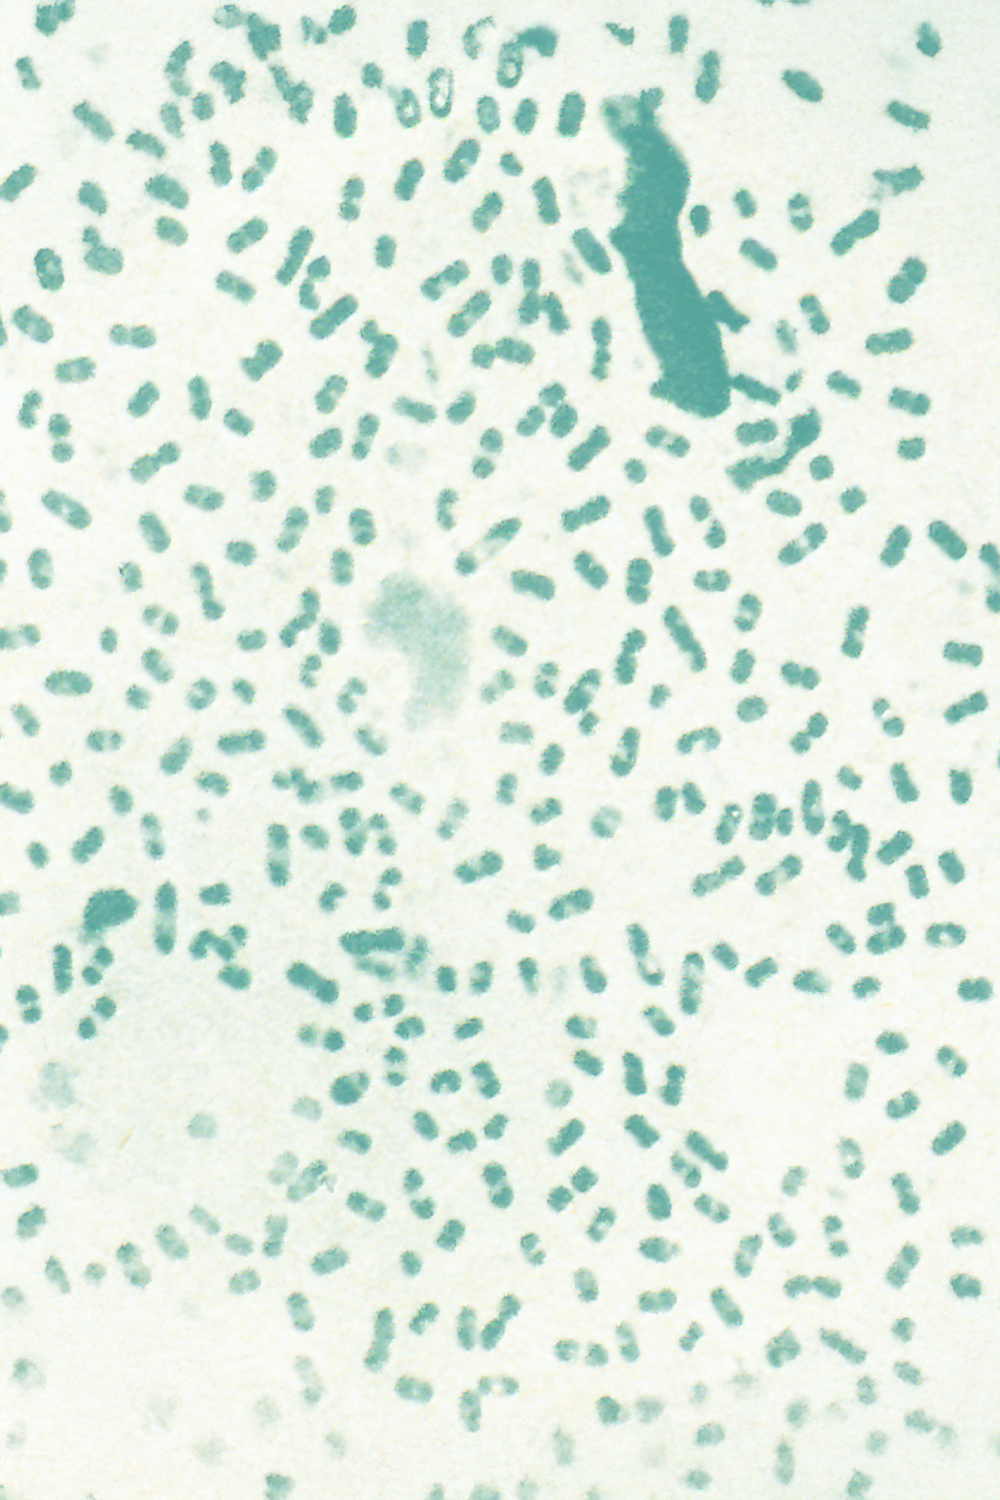

Objectif
un don
Ensemble,
sauvons notre santé

Pourquoi est-il urgent d'agir ?
d’ici 2050
la maladie d’Alzheimer
en croissance, maladies infectieuses en hausse...
N’attendons pas qu’il soit trop tard pour SAUVER NOTRE SANTÉ.

Marie-Anne Rameix-Welti,
Virologue et chercheuseà
l’Institut Pasteur.


lutter contre la bronchiolite


MALADIES INFECTIEUSES :
lutter contre la bronchiolite
Le virus respiratoire syncytial est le principal responsable de la bronchiolite du nourrisson qui peut être très sévère voire entraîner le décès. Avec son équipe, Marie-Anne Rameix-Welti s’intéresse à des compartiments particuliers de la cellule où ce virus se multiplie. Ils ont créé des outils innovants pour visualiser la circulation des virus et mieux comprendre les mécanismes en jeu dans leur multiplication.
LES OBJECTIFS de recherche de Marie-Anne Rameix-Welti :
- Comprendre les étapes les moins connues de la multiplication du virus.
- Mettre au point des vaccins et des antiviraux plus efficaces dans la durée.

Jean-Baptiste Masson,
Physicien théoricien etchercheur
à l'Institut Pasteur.


des cancers rares ou complexes


CANCERS :
améliorer la détection des cancers rares ou complexes
Jean-Baptiste Masson et son équipe souhaitent améliorer les algorithmes grâce à l'Intelligence Artificielle pour la détection des cancers rares ou complexes. La création de modèles numériques des tumeurs, couplée à l'ensemble des analyses réalisées sur les cancers, permettra une meilleure prise en charge et une adaptation des traitements au plus près des besoins des patients.
LES OBJECTIFS de recherche de Jean-Baptiste Masson :
- Améliorer les algorithmes de détection en utilisant l'IA et les bases de données déjà disponibles.
- Créer des modèles numériques des tumeurs.
- Rendre les diagnostics plus précis et les traitements plus personnalisés.

Mariana Alonso,
Neuroscientifique et chercheuseà l’Institut Pasteur.


comprendre et stimuler la
neurogenèse


MALADIES neurodégénératives :
comprendre et stimuler la neurogenèse
La neurogenèse est la capacité du cerveau humain à produire de nouveaux neurones, et ce tout au long de notre vie. Ce processus joue un rôle clé dans la mémoire ou encore l’apprentissage. Nous savons aujourd’hui que la production de nouveaux neurones diminue de façon précoce chez les patients atteints de la maladie d’Alzheimer et pourrait aussi jouer un rôle dans la maladie de Parkinson.
Mariana Alonso et son équipe travaillent pour déchiffrer les mécanismes de formation et la fonction de ces jeunes neurones dans le cerveau adulte. Comprendre et stimuler la neurogenèse ouvre un potentiel inédit pour améliorer le traitement des maladies cérébrales.
LES OBJECTIFS de recherche de Mariana Alonso :
- Identifier les mécanismes précis qui régissent le processus de la neurogenèse.
- Comprendre leur potentiel pour ralentir la progression des maladies neurodégénératives.
- Améliorer la qualité de vie des personnes âgées en préservant leur plasticité cérébrale et leur santé mentale.


Vous aussi, vous avez
le pouvoir d'agir.
Chaque don permet d’accélérer nos recherches et de faire avancer les découvertes sur des maladies qui nous concernent tous.
Faites un don avant
le 31 décembre
pour profiter d’une déduction fiscale
Fondation reconnue d’utilité publique, l’Institut Pasteur
est habilité à recevoir des
dons sur lesquels vous pouvez bénéficier de déductions fiscales.

du montant de votre don à l’Institut Pasteur
sont déductibles de
votre Impôt sur le Revenu (IR),
dans la limite de 20 % de votre revenu
imposable.
du montant de votre don à l’Institut Pasteur sont
déductibles de
votre Impôt sur la Fortune Immobilière (IFI),
dans la limite de 50 000 €.
L'institut pasteur
c'est
près de 140 ans de
découvertes


-
1885
Mise au point du vaccin contre la rage
-
1894
Identification du bacille de la peste
-
1921
Mise au point du
BCG -
1932
Mise au point d’un vaccin contre la fièvre jaune
-
1954
Mise au point d’un vaccin contre la poliomyélite
-
1983
Découverte du virus du sida (VIH)
-
1985
Mise au point d’un vaccin contre l’hépatite B
-
1989
Mise au point d’un test de diagnostic rapide de la tuberculose
-
1995
Identification de gènes responsables de surdités héréditaires
-
2006
Détermination de l’histoire évolutive du virus Chikungunya
-
2008
Nouvelle source de neurones identifiée dans le cerveau adulte
-
2009
Mise au point d’un test rapide du virus A(H1N1)
-
2014
Identification d’une nouvelle variante du virus Ebola en Guinée
-
2019
Nouvelles pistes contre le VIH/sida
-
2020
Séquençage du génome complet du SARS-CoV-2
-
2021
Mobilisation de 500 chercheurs contre la Covid-19
-
2023
Découverte du mode d’action d’immunothérapies de cancers du sang.

MALADIES INFECTIEUSES :
lutter contre la bronchiolite
Le virus respiratoire syncytial est le principal responsable de la bronchiolite du nourrisson qui peut être très sévère voire entraîner le décès. Avec son équipe, Marie-Anne Rameix-Welti s’intéresse à des compartiments particuliers de la cellule où ce virus se multiplie. Ils ont créé des outils innovants pour visualiser la circulation des virus et mieux comprendre les mécanismes en jeu dans leur multiplication.
LES OBJECTIFS de recherche de Marie-Anne Rameix-Welti :
- Comprendre les étapes les moins connues de la multiplication du virus.
- Mettre au point des vaccins et des antiviraux plus efficaces dans la durée.

CANCERS :
améliorer la détection des cancers rares ou complexes
Jean-Baptiste Masson et son équipe souhaitent améliorer les algorithmes grâce à l'Intelligence Artificielle pour la détection des cancers rares ou complexes. La création de modèles numériques des tumeurs, couplée à l'ensemble des analyses réalisées sur les cancers, permettra une meilleure prise en charge et une adaptation des traitements au plus près des besoins des patients.
LES OBJECTIFS de recherche de Jean-Baptiste Masson :
- Améliorer les algorithmes de détection en utilisant l'IA et les bases de données déjà disponibles.
- Créer des modèles numériques des tumeurs.
- Rendre les diagnostics plus précis et les traitements plus personnalisés.

MALADIES neurodégénératives :
comprendre et stimuler la neurogenèse
La neurogenèse est la capacité du cerveau humain à produire de nouveaux neurones, et ce tout au long de notre vie. Ce processus joue un rôle clé dans la mémoire ou encore l’apprentissage. Nous savons aujourd’hui que la production de nouveaux neurones diminue de façon précoce chez les patients atteints de la maladie d’Alzheimer et pourrait aussi jouer un rôle dans la maladie de Parkinson.
Mariana Alonso et son équipe travaillent pour déchiffrer les mécanismes de formation et la fonction de ces jeunes neurones dans le cerveau adulte. Comprendre et stimuler la neurogenèse ouvre un potentiel inédit pour améliorer le traitement des maladies cérébrales.
LES OBJECTIFS de recherche de Mariana Alonso :
- Identifier les mécanismes précis qui régissent le processus de la neurogenèse.
- Comprendre leur potentiel pour ralentir la progression des maladies neurodégénératives.
- Améliorer la qualité de vie des personnes âgées en préservant leur plasticité cérébrale et leur santé mentale.

















